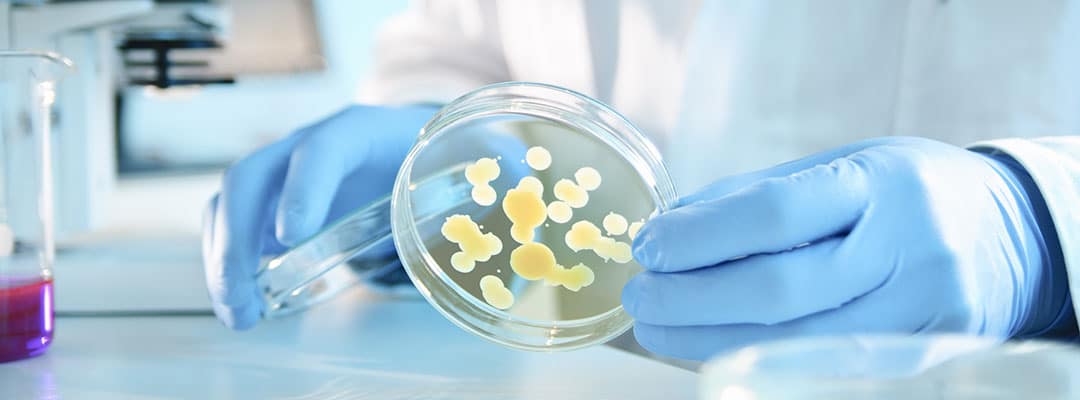
bannière agents biologiques

On parle de “risque biologique en milieu professionnel” lorsqu’une personne est susceptible d’être exposée, dans le cadre de son travail, à un ou plusieurs agents biologiques pouvant nuire à sa santé. Mais savons-nous réellement ce qu’est un agent biologique ?
Définition d’un agent biologique
On regroupe dans le terme “agents biologiques” les micro-organismes naturels et génétiquement modifiés, les cultures cellulaires, les endoparasites et les agents transmissibles non-conventionnels (également appelés prions).
Par micro-organismes, on entend les entités microbiologiques capables de se reproduire ou de transférer leur matériel génétique. Cela inclut donc les micro-organismes cellulaires (bactéries, levures, champignons) et non-cellulaires (virus).
Bien que la majorité des agents biologiques soient inoffensifs pour l’Homme, certains sont pathogènes, c’est à dire susceptibles de provoquer chez leur hôte une infection, une allergie (exemple : asthme, rhinite), une intoxication, ou encore d’autres pathologies (cancer ou immunosuppression).
| Agents biologiques | Description | Exemples d’agents pathogènes | Types de pathologies potentielles pour les espèces pathogènes |
|---|---|---|---|
| Bactéries | Micro-organismes composés d’une seule cellule (1 à 10 micromètres), en forme de bâtonnet (alors appelés bacilles) ou de forme sphérique (appelés coques). | Bacilles : Mycobacterium tuberculosis agent de la tuberculose. Coques : Staphylococcus aureus (ou staphylocoque doré). | – Infection – Intoxication – Allergies – Cancérigène |
| Virus | Entités (autour de 0,1 micromètre) ne pouvant vivre et se multiplier qu’à l’intérieur d’une cellule vivante spécifique de l’homme, d’animaux, d’insectes, de plantes ou de micro-organismes. | VHB ou virus de l’hépatite B, virus de la varicelle et du zona. Sars-cov-2, virus de la COVID-19. | – Infection – Cancérigène – Immunosuppresseur |
| Champignons microscopiques | Micro-organismes (1 à 100 micromètres) pouvant être composés d’une cellule (les levures) ou de plusieurs cellules (les moisissures). Les spores de champignons (ou spores fongiques) se dispersent facilement et participent à leur grande dissémination dans l’environnement. | Moisissures : Aspergillus et Penicillium. Levures : Candida et Cryptococcus. | – Infection – Intoxication – Allergies – Cancérigène |
| Endoparasites | Protozoaires : constitués d’une cellule avec noyau, présentant une très grande diversité (de 10 micromètres à 2 cm). Helminthes : vers aplatis ou cylindriques (de 50 micromètres à 8 m). | Toxoplasma gondii (agent de la toxoplasmose). Tænias, douves, ascaris et oxyures. | – Infection |
| ATNC | Protéines (autour de 0,01 micromètre) responsables de maladies dégénératives du système nerveux central chez l’homme et les animaux. | Agent de la maladie de Creutzfeldt-Jakob chez l’Homme. | – Infection |
Source des trois premières colonnes : INRS
La classification des agents biologiques
La réglementation (article R4421-3 du code du travail) permet une classification des agents biologiques en 4 groupes de risques croissants, basée sur trois critères : 1) leur pathogénicité pour l’Homme, 2) le risque de dissémination dans la collectivité, et 3) l’existence d’une prophylaxie* ou d’un traitement efficace.
*Prophylaxie : ensemble de moyens destinés à prévenir l’apparition, la propagation ou l’aggravation des maladies.Les agents biologiques non-pathogènes sont classés dans le groupe 1. Il n’existe pas de liste exhaustive pour ces agents biologiques car ils sont innombrables.

Seuls les agents des groupes 2 à 4 sont pathogènes pour l’Homme.
Le groupe 2 comprend donc des agents biologiques pouvant provoquer une maladie chez l’Homme mais dont la propagation dans la collectivité est peu probable. Pour les agents biologiques de ce groupe, il existe généralement une prophylaxie et/ou un traitement efficace.
Le groupe 3 comprend les agents biologiques pouvant provoquer une maladie grave chez l’Homme. Leur propagation dans la collectivité est possible, mais il existe généralement une prophylaxie et/ou un traitement efficace.
Enfin, le groupe 4 comprend également les agents biologiques pouvant provoquer une maladie grave chez l’Homme et leur propagation dans la collectivité est élevée, de plus il n’existe généralement ni prophylaxie ni traitement.
Il faut noter que l’appartenance à l’un de ces groupes n’est pas figée ; en fonction de l’avancée des connaissances, la classification d’un agent biologique donné peut être amenée à varier.
Lorsque vous travaillez avec un agent non encore classé, il est recommandé de ne pas le considérer par défaut comme non dangereux (groupe 1). Sa classification doit résulter de l’évaluation basée sur les critères mentionnés précédemment.
Il est important de noter que chaque agent est classé selon l’évaluation de la pathogénicité pour une personne en bonne santé. En effet, elle peut varier selon l’état de santé de chacun (immunosuppression, grossesse, etc.). C’est pourquoi un suivi individuel de santé est réalisé régulièrement pour tout salarié exposé aux agents biologiques des groupes 2, 3 et 4.
Chaîne de transmission
La transmission d’un agent biologique fait intervenir six composants.

On appelle l’ensemble “la chaîne de transmission de l’agent biologique”. Pour qu’il y ait transmission, il faut bien sûr qu’il y ait un agent biologique (1) dans la chaîne (exemples : virus Sars-cov-2, bactérie Yersinia pestis, …).
Le réservoir (2) est spécifique de chaque agent (humain, animal, …). Par exemple, le réservoir du virus Sars-cov-2 est l’Homme. Pour la bactérie Yersinia pestis, agent biologique de la peste, les réservoirs sont les rongeurs (rats, souris…).
La porte de sortie (3) est la voie par laquelle l’agent biologique quitte le réservoir. Pour le virus Sars-cov-2 , ce sont les voies respiratoires (éternuements, toux). Pour la bactérie Yersinia pestis, la porte de sortie est la puce dans laquelle va transiter l’agent biologique avant d’atteindre son hôte récepteur final.Dans le cas de la transmission à l’Homme, le mode de transmission (4) peut se faire :
- par inhalation de particules ou de gouttelettes véhiculant l’agent biologique (exemple : Sars-cov-2, virus de la COVID-19),
- par inoculation via une blessure, une morsure ou une piqûre d’insecte (exemple : Yersinia pestis, bactérie transmise à l’Homme par piqûre de puces et responsables de la peste ou encore Plasmodium, parasite transmis à l’homme par une piqûre de moustique et responsable du Paludisme),
- par ingestion d’aliments contaminés (fromages ou charcuteries contaminés par des Salmonelles), d’eau contaminées (Vibrio cholerae) , ou en se rongeant les ongles sales, en portant un stylo contaminé à la bouche (contamination par des Salmonelles ou d’autres Entérobactéries).
- par contact direct avec la peau et les muqueuses (peau, yeux, nez…) en y portant des mains contaminées ou un objet contaminés (exemple : infection de l’oeil par Staphylococcus aureus, bactérie responsable de l’orgelet après contact avec des mains contaminées).
Pour l’Homme (6), les portes d’entrées (5) sont directement liées aux modes de transmission : voie respiratoire ou aérienne pour une transmission par inhalation, voie cutanée ou transcutanée pour une transmission par inoculation ou contact direct avec les muqueuses, et voie orale ou digestive pour une ingestion.

Voie respiratoire/aérienne

Voie orale/digestive

Voie cutanée/transcutanée
Prévention des risques biologiques
La prévention des risques biologiques en entreprise consiste à rompre la chaîne de transmission le plus en amont possible par la mise en place de mesures de prévention : confinement, organisation du travail, mise à disposition d’équipements de protection collective et individuelle, méthodes de désinfection, et bien sûr formation du personnel.
Sources :
- Références au Code du travail non exhaustives à retrouver sur www.legifrance.gouv.fr :
- Définition et classement des agents biologiques : Articles R.4421-2 et R.4421-3 du Code du travail.
- Évaluation du risque biologique : Articles R.4423-1 à R.4423-4 du Code du travail.
- Prévention des risques biologiques : Articles R. 4421-1 à R. 4427-5 du Code du travail.
- Surveillance médicale : article R. 4426-1 à R.4426-13 du Code du travail.
- Recommandations vaccinales du ministère de la santé de l’année en cours : Articles L.3111-4 et L.3112 du Code de santé publique.